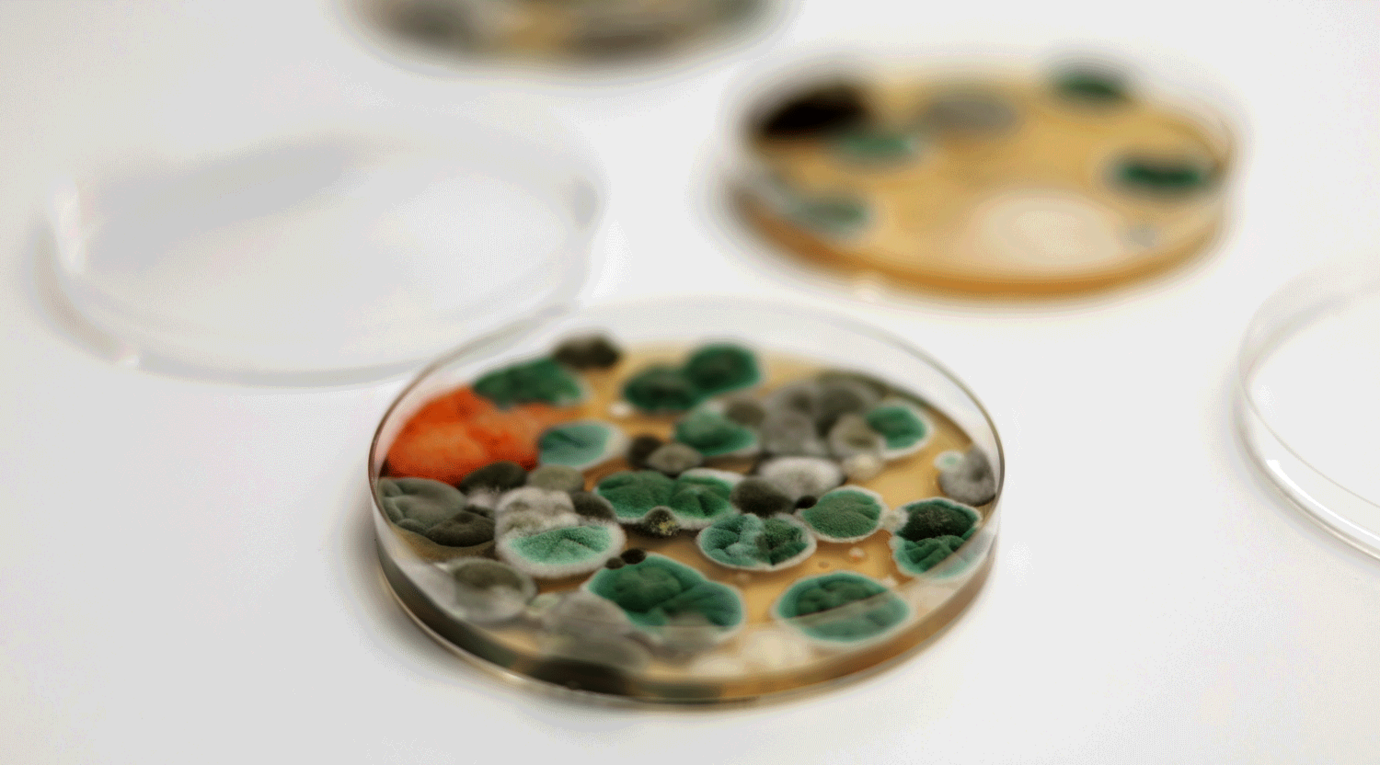

Klimadatenlogging
Gesundes Raumklima entsteht durch gezielten Luftaustausch. Je luftdichter wir unsere Häuser bauen, desto weniger ist ein notwendiger, natürlicher Luftaustausch gegeben. Das Raumklima verschlechtert sich dann oft sehr schnell und Feuchtigkeit, Kondenswasser setzen sich fest. Dies bietet optimale Vorraussetzungen für das Wachstum von Schimmelpilzen.
Das LOCATEC-Klimadatenlogging sorgt für Gewissheit.
Hierbei zeichnen wir, mit modernster Technik, über einen Zeitraum von 21 Tagen alle relevanten Klima- und Temperaturdaten im Gebäude auf, können dadurch Schwankungen sowie potenzielle Risiken erkennen und Ihnen ganzheitliche, nachhaltige Lösungswege aufzeigen.
Das ist der Ablauf:
Bestandsaufnahme
Im Rahmen unseres Vorab-Systemchecks nehmen wir den Ist-Zustand vor Ort auf und beraten Sie ausführlich.
Datensammlung
Aufzeichnung aller relevanten Klimadaten der Wohnung, mittels geeichter Klimadatenlogger, meist über einen Zetraum von 21 Tagen.
Auswertung
Analyse und Auswertung aller relevanten Daten in Berichtsform. Daraus folgt eine Abteilung von Empfehlungen und weiteren Vorgehensweisen.
Nachgespräch
Auf Kundenanfrage besprechen wir gerne mit Ihnen die Ergebnisse und erläutern Ihnen mögliche Lösungswege.
Schimmelerstmaßnahmen
Ist ein Schimmelschaden bereits eingetreten, so ist schnelles Handeln gefragt, denn für eine effektive Gesundheitsvorsorge ist die Beseitigung von Schimmelpilzen in Innenräumen dringend notwendig!
Bei konventionellen Methoden werden zunächst Produkte wie Wasserstoffperoxid oder Alkohol verwendet. Hierbei können aber lose Sporen durch das Besprühen der kontaminierten Flächen über den Luftweg weiterverbreitet werden. Die Folge: die Raumluft wird zusätzlich belastet und die Sporen können sich an anderen Stellen festsetzen.
Die LOCATEC-Schimmelerstmaßnahmen verhindern eine weitere Ausbreitung der Schimmelsporen. Durch einen Sanierungsfilm, der nicht aufgesprüht, sondern auf die betroffene Fläche aufgerollt wird, werden alle kontaminierten Bestandteile gebunden und lose Sporen verkapselt. Dies verschafft Ihnen Zeit, da die Schadstoffe fachgerecht und sicher isoliert bleiben, bis eine Begutachtung des Schadens durch einen Sachverständigen erfolgen kann.
LOCATEC − und dem Schimmel bleibt die Luft weg
Der von uns verwendete Sanierungsfilm ist eine flüssige Suspension – eine partikelbindende Erstmaßnahme zur desodorierenden Reinigung von verschimmelten Oberflächen und zur Entfernung von Staubbelastungen. Nach dem Trocknen bildet sich ein elastischer, abziehbarer Film, der Staub, Sporen und andere Schimmelpilzgeflechte fest bindet und zugleich Oberflächen reinigt.
Innerhalb von max. 12 Stunden ist der Film trocken und verschließt damit die Schadstelle sicher. Der Sanierungsfilm kann 14 Tage und länger an der Stelle verbleiben – genug Zeit, um über die weitere Vorgehensweise und mögliche Sanierungsmaßnahmen zu entscheiden.
Der LOCATEC-Reparaturschnellservice
Leckage stoppen - Versorgung sicherstellen
Wenn Ihnen eine eigene Notlösung für eine schnelle Reparatur von bereits georteten Leitungswasserschäden fehlt und Ihr Installateur keinen kurzfristigen Termin anbieten kann, lösen wir Ihr Problem!
Unsere Servicetechniker stoppen zunächst den weiteren Wasseraustritt durch eine provisorische Notabdichtung, wodurch zusätzliche Schäden vermieden werden. Eine Aufrechterhaltung der Wasserversorgung, sodass Sanitäranlagen weiterhin nutzbar bleiben, ist dadurch gewährleistet.
Unsere Leistungen im Überblick:
- Schnelle, punktgenaue Ortung der Leckage
- Notabdichtung für Schadensfälle, die innerhalb von 24 Stunden nicht repariert werden können
- Durchführung provisorischer Sofortmaßnahmen, wodurch eine fachgerechte Reparatur durch Ihren Hausinstallateur in Ruhe terminiert werden kann
- Die Abstimmung und Kommunikation mit Nachfolgegewerken, die bei der Wiederherstellung des Vorschadenzustands zum Einsatz kommen
Professionelle Poolleckortung bei Wasserverlust –
LOCATEC findet das Leck punktgenau
Verlieren Sie Wasser in Ihrem Schwimmbad oder Pool? Ein kontinuierlicher Wasserverlust kann auf undichte Stellen in der Poolverrohrung, der Poolpumpe oder an der Sandfilteranlage hinweisen. Solche Leckagen bleiben oft lange unbemerkt und können zu hohen Folgekosten führen.
Mit LOCATEC haben Sie einen erfahrenen Partner an Ihrer Seite:
Unsere Experten sind spezialisiert auf die Leckortung an Pools, Schwimmbecken und Außenanlagen – präzise, zerstörungsfrei und zuverlässig.
Wir orten Lecks schnell und punktgenau, um den Aufwand für Reparaturen so gering wie möglich zu halten. Ob privater Swimmingpool oder gewerblich genutzte Anlage – wir finden die undichte Stelle.
Sie vermuten ein Poolleck?
Kontaktieren Sie uns – wir kümmern uns um eine zielgenaue Diagnose vor Ort.